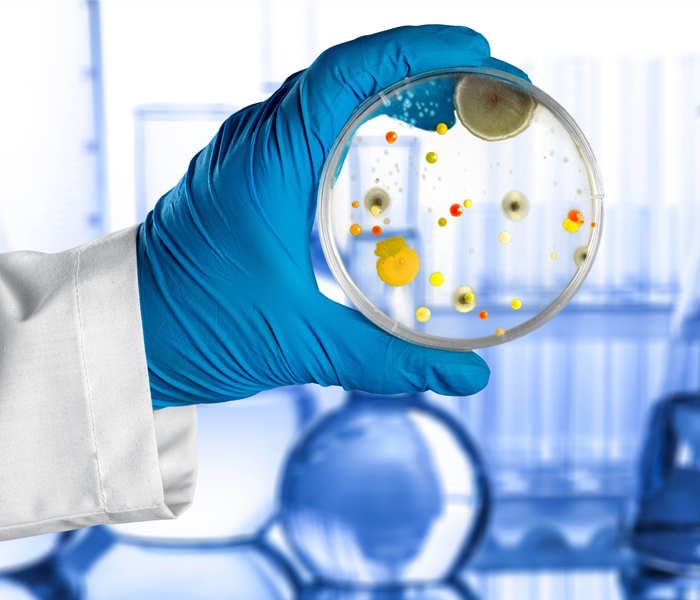
Image

Alcohols
Alcohols can be thought of as derivatives of alkanes where a hydrogen atom has been replaced by a hydroxyl group.

Emulsifiers
Emulsifiers are substances that stabilize emulsions by holding together liquids that normally separate, like oil and water

Ethers
They are known for being relatively unreactive, making them useful as solvents for a wide range of substances like fats, oils, waxes, and resins.

Esters
Esters have a wide range of uses, including as fragrances and flavors in foods and perfumes, as industrial solvents.

Glycols
Glycols, most commonly ethylene glycol, are prepared industrially through the hydrolysis of an epoxide intermediate.

Hydrocarbons
Hydrocarbons are widely used as fuels (like natural gas, gasoline, and propane) and are the source material for many other organic
Hygiene
In medicine and everyday life, hygiene practices are preventive measures that reduce the incidence

Ketones
Ketones are formed through the metabolic process of ketogenesis in the liver, which happens when the body's glucose is low.

Laboratory and Analytical Reagents
Laboratory and analytical reagents are chemical substances used to detect, measure, or test for other substances in a laboratory setting

Oil and Wax
Waxes are very much like fats or oil, except that they are malleable in normal conditions, and have only single long-chain fatty acid

Phenols And Cresols
Phenols and cresols are both organic compounds with a hydroxyl group attached to a benzene ring, but cresols are a specific type of phenol

Polymers
They can be natural (like DNA, silk, and proteins) or synthetic (like nylon, polyethylene, and polyester)
Silicones
Silicones are versatile synthetic polymers made of alternating silicon and oxygen atoms in a backbone

Surfactants
Surfactants, or surface-active agents, are compounds that reduce the surface tension of a liquid

Terpenes
Terpenes are major biosynthetic building blocks. Steroids, for example, are derivatives of the triterpene squalene.

Thinner
Thinner is manufactured by blending specific solvents in precise proportions, typically involving mixing raw materials like toluene
